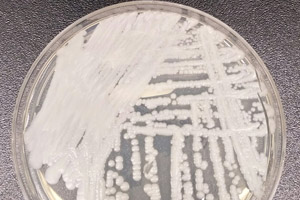

By Sara DiNatale
Mississippi Today
Mississippi is battling an outbreak of C. auris, a fungal infection resistant to medication, which the Department of Health says may be responsible for the deaths of four people.
“Our investigation is ongoing and fluid,” said health department spokesperson Liz Sharlot.
Sharlot said the department has identified 12 clinical cases of the infection and four “potentially associated deaths.” Both those numbers doubled since State Epidemiologist Dr. Paul Byers last gave a report about the infections to the Board of Health in January.
C. auris is still rare in the United States. The people most vulnerable to an invasive infection – such as in the blood, heart or brain — are already sick from other medical conditions.
At the center of the Mississippi outbreak is a long-term care facility in central Mississippi. Some patients with the infection have also received care at the University of Mississippi Medical Center in Jackson.
When patients with a C. auris infection arrive at the hospital, they are each assigned one nurse who cares for them exclusively, according to UMMC Chief Medical Officer Dr. Lisa Didion.
“That’s how dangerous this is,” Didion said last week during a Mississippi Institutions of Higher Learning Health Affairs Committee meeting.
Doctors first identified C. auris — or Candida auris — in Asia in 2009. It has quickly become a cause of severe infections around the world with some strains resistant to all three available classes of antifungals.

The yeast — a type of fungus — can be carried on patients’ skin without causing infection or symptoms, allowing it to easily spread to others.
The Department of Health says it has identified 53 “colonized” patients, meaning patients who aren’t sick with an active infection but were found to be carrying the organism somewhere on their body. That number was 37 about four weeks ago.
“When we get patients from that facility (in Central Mississippi), we really have to be sure that we isolate them appropriately,” Didion said of the care at UMMC. “This particular organism is extremely transmissible and has a very high mortality rate.”
The CDC has found that C. auris spreads most often in long-term health care facilities among patients with severe medical problems. The fungus can cause bloodstream infections and death. More than 1 in 3 patients with an invasive infection of C. auris will die, according to CDC research.
Mississippi’s first cases were identified in November 2022, Byers wrote in a January update on the outbreak.
“This is a rapidly expanding and serious situation,” Byers said at the time.
The majority of cases are based in one long-term care facility but a second central Mississippi facility has some patients with detected colonization. A handful of other cases have been reported at other health care facilities across the state, according to Byers’ update.
C. auris is resistant to some commonly used disinfectants. In response, the health department has asked health care facilities across the state to obtain the appropriate products in preparation should the outbreak grow.
Didion said while they have treated patients with the infection, they have had no transmission of the fungus within the hospital so far.
“But it is a reason to stay focused,” she said.
This article first appeared on Mississippi Today and is republished here under a Creative Commons license.